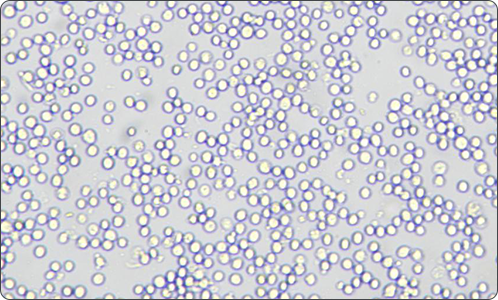
新品上市 | 動態(tài)細胞成像儀

9月初秋
縷縷秋風吹拂著新品上方的紗幔
紗幔飛,新品至
D1-動態(tài)細胞成像儀
匠心之作,震撼來襲

博大博聚,D1-動態(tài)細胞成像儀
配合高倍光學放大+一千萬彩色相機,
讓細胞成像更清晰、數據分析更精準。
產品特點
01、開放式載物臺
兼容培養(yǎng)板、培養(yǎng)皿等容器

02、緊湊型設計
可放入二氧化碳培養(yǎng)箱,
進行細胞動態(tài)觀察。

03、10X光學放大+一千萬彩色相機
儀器內置10X光學放大+一千萬彩色相機,細胞
成像更清晰,數據分析更精準;軟件支持圖像
在線制成媒體視頻。
04、智能軟件分析
智能軟件識別分析拍攝圖像,自動分析細胞直徑、細胞
密度、匯合度等指標,繪制各項分析圖表。

博大博聚-動態(tài)細胞成像儀
適用于類器官分析、細胞動態(tài)觀察等
助力細胞分析自動化
快來聯系我們吧